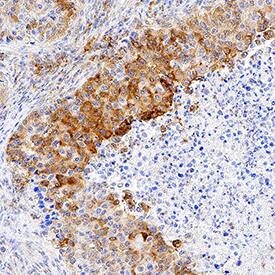
Ephrin-A4 antibody in Human Squamous Cell Carcinoma by Immunohistochemistry (IHC-P).

Human Ephrin-A4 Antibody
R&D Systems, part of Bio-Techne | Catalog # MAB3692


Key Product Details
Species Reactivity
Applications
Label
Antibody Source
Product Specifications
Immunogen
Leu26-Gly171
Accession # P52798
Specificity
Clonality
Host
Isotype
Scientific Data Images for Human Ephrin-A4 Antibody
Ephrin‑A4 in MCF‑7 Human Cell Line.
Ephrin-A4 was detected in immersion fixed MCF-7 human breast cancer cell line using Mouse Anti-Human Ephrin-A4 Monoclonal Antibody (Catalog # MAB3692) at 8 µg/mL for 3 hours at room temperature. Cells were stained using the NorthernLights™ 557-conjugated Anti-Mouse IgG Secondary Antibody (red; Catalog # NL007) and counterstained with DAPI (blue). Specific staining was localized to cytoplasm. View our protocol for Fluorescent ICC Staining of Cells on Coverslips.Ephrin‑A4 in U‑87 MG Human Cell Line.
Ephrin-A4 was detected in immersion fixed U-87 MG human glioblastoma/astrocytoma cell line using Mouse Anti-Human Ephrin-A4 Monoclonal Antibody (Catalog # MAB3692) at 8 µg/mL for 3 hours at room temperature. Cells were stained using the NorthernLights™ 557-conjugated Anti-Mouse IgG Secondary Antibody (red; Catalog # NL007) and counterstained with DAPI (blue). Specific staining was localized to cytoplasm. View our protocol for Fluorescent ICC Staining of Cells on Coverslips.Ephrin‑A4 in Human Squamous Cell Carcinoma.
Ephrin-A4 was detected in immersion fixed paraffin-embedded sections of human squamous cell carcinoma using Mouse Anti-Human Ephrin-A4 Monoclonal Antibody (Catalog # MAB3692) at 5 µg/mL for 1 hour at room temperature followed by incubation with the Anti-Mouse IgG VisUCyte™ HRP Polymer Antibody (Catalog # VC001). Tissue was stained using DAB (brown) and counterstained with hematoxylin (blue). Specific staining was localized to cytoplasm in cancer cells. View our protocol for IHC Staining with VisUCyte HRP Polymer Detection Reagents.Applications for Human Ephrin-A4 Antibody
Immunocytochemistry
Sample: Immersion fixed MCF‑7 human breast cancer cell line and U‑87 MG human glioblastoma/astrocytoma cell line
Immunohistochemistry
Sample: Immersion fixed paraffin-embedded sections of human squamous cell carcinoma
Reviewed Applications
Read 1 review rated 5 using MAB3692 in the following applications:
Formulation, Preparation, and Storage
Purification
Reconstitution
Formulation
Shipping
Stability & Storage
- 12 months from date of receipt, -20 to -70 °C as supplied.
- 1 month, 2 to 8 °C under sterile conditions after reconstitution.
- 6 months, -20 to -70 °C under sterile conditions after reconstitution.
Background: Ephrin-A4
Two distinct types of receptors that bind the pleiotropic cytokines IL-1 alpha and IL-1 beta have been described. The IL-1 receptor Type I is an 80 kDa transmembrane protein that is expressed predominantly by T cells, fibroblasts, and endothelial cells. IL-1 receptor Type II is a 68 kDa transmembrane protein found on B lymphocytes, neutrophils, monocytes, large granular leukocytes and endothelial cells. Both receptors are members of the immunoglobulin superfamily and show approximately 28% sequence identity in their extracellular domains. The two receptor types do not heterodimerize into a receptor complex. An IL-1 receptor accessory protein that can heterodimerize with the Type I receptor in the presence of IL-1 alpha or IL-1 beta but not IL-1ra, was identified (1). This Type I receptor complex appears to mediate all the known IL-1 biological responses. The receptor Type II has a short cytoplasmic domain and does not transduce IL-1 signals. In addition to the membrane-bound form of IL-1 RII, a naturally-occurring soluble form of IL-1 RII has been described. It has been suggested that the Type II receptor, either as the membrane-bound or as the soluble form, serves as a decoy for IL-1 and inhibits IL-1 action by blocking the binding of IL-1 to the signaling Type I receptor complex. Recombinant IL-1 soluble receptor Type I is a potent antagonist of IL-1 action.
References
- Greenfeder, S. et al. (1995) J. Biol. Chem. 270:13757.
Alternate Names
Gene Symbol
UniProt
Additional Ephrin-A4 Products
Product Documents for Human Ephrin-A4 Antibody
Product Specific Notices for Human Ephrin-A4 Antibody
For research use only